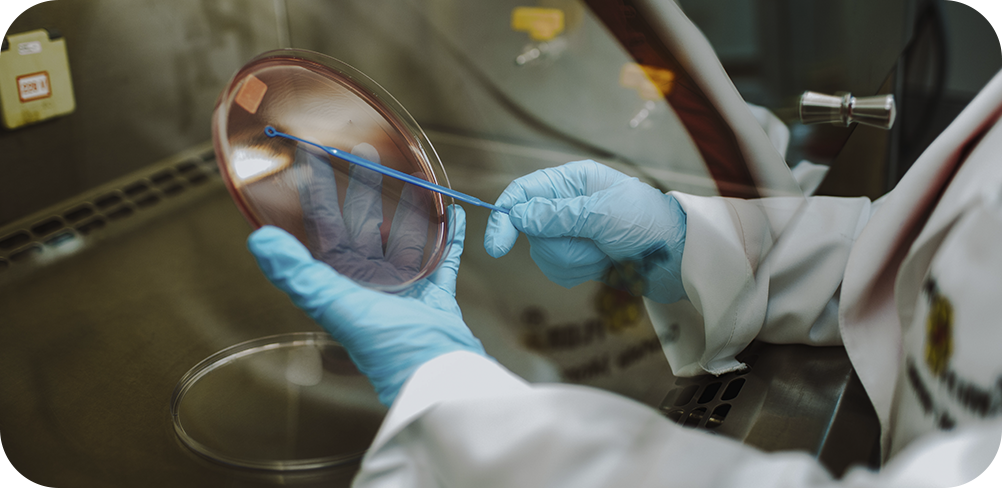

Pesquisa

PROPOMAX® Clinical Regeneración de la Voz es un spray antiséptico natural, fabricado mediante procesos de alta tecnología que garantizan todos los beneficios de cada principio activo presente en el producto.
Combinando eficazmente el extracto de propóleo verde EPP-AF®, hierba de los cantores, jengibre y miel, el PROPOMAX® Clinical Recuperación de la Voz tiene un 99% de eficacia contra las bacterias causantes de problemas bucales, como Staphylococcus aureus y Streptococcus mutans.
Además, la combinación de estos activos naturales del PROPOMAX® Clinical Spray ayuda en la recuperación de la voz y proporciona confort inmediato, ofreciendo protección y revitalización para quienes necesitan usar la voz en su día a día.
MODO DE USO: Aplicar de tres a cuatro veces en la boca, cuando sea necesario. Agitar antes de usar.

ACCIÓN ANTISÉPTICA COMPROBADA
El poder antiséptico de los sprays PROPOMAX® Clinical está garantizado por rigurosos análisis de eficacia en laboratorio frente a las principales bacterias responsables de problemas bucales, como Staphylococcus aureus y Streptococcus mutans.
Las pruebas se realizan en nuestros laboratorios de Control de Calidad Microbiológico y Fisicoquímico, que cuentan con equipos de última generación, estandarizados conforme a normas internacionales, garantizando el estándar de calidad de cada producto.

Además, nuestros laboratorios están reconocidos por el Ministerio de Agricultura y cumplen todas las normas establecidas por Anvisa para los análisis, desde la recepción de la materia prima y el seguimiento de la producción hasta la liberación del producto terminado.
Dentro del laboratorio microbiológico de Apis Flora, realizamos la prueba de halo de inhibición, una técnica que comprueba la eficacia del producto. En este análisis, se coloca una muestra de cultivo bacteriano en una placa de Petri y se aplica una pequeña cantidad de tres sustancias distintas: el producto, un control positivo y un control negativo. Los controles positivo y negativo sirven para asegurar la confiabilidad del experimento. La conclusión de la prueba se da al observar si la cantidad aplicada del producto es capaz de impedir el crecimiento bacteriano. Si el producto posee actividad antiséptica, se formará una "zona de inhibición" alrededor del área de aplicación, lo que comprueba su eficacia. A esta zona de inhibición se la denomina halo de inhibición.



Propolis extract (extracto de propóleo), Zingiber officinale extract (extracto de jengibre), Sisybrium officinale extract (extracto de rinchão o heirba de lo cantantes), Mentha piperita oil (aceite de menta), Eugenia caryophyllus oil (aceite de clavo de olor), honey (miel), xylitol (xilitol), xanthan gum (goma xantana) y aqua (agua).
INFORMACIONES IMPORTANTES
![]() Evitar el contacto con los ojos
Evitar el contacto con los ojos![]() Suspender el uso en caso de sensibilización
Suspender el uso en caso de sensibilización![]() Conservar en un lugar fresco
Conservar en un lugar fresco

Combinando extracto de propóleo verde EPP-AF®, hierba de los cantores, jengibre y miel, el PROPOMAX® Clinical Regeneración de la Voz protege y revitaliza la voz, ayudando en la recuperación y proporcionando alivio inmediato.



La Sisymbrium officinale – planta medicinal de la familia de la col y la mostaza – tiene utilidad más allá de las preparaciones culinarias. Con tradición histórica de uso para enfermedades de la garganta, como la afonía y la ronquera, se hizo popularmente conocida como hierba de los cantantes. Su presencia en el PROPOMAX® Clinical Regeneración de la Voz, otorga al producto propiedades biológicas como antimicrobiana, antiinflamatoria y relajante muscular.

El jengibre (Zingiber officinale), es una planta originaria de Asia y, desde la antigüedad, se ha utilizado para combatir enfermedades. Los estudios han demostrado que el jengibre posee acciones terapéuticas como antimicrobiana y antiinflamatoria.

El propóleo verde es especial por dos razones principales: las abejas africanizadas y las fuentes únicas de flora brasileña. Es producido a partir de los exudados recolectados por las abejas exclusivamente de una planta nativa de Brasil, la Baccharis dracunculifolia, popularmente conocida como Vassourinha o Alecrim do Campo.
Contiene compuestos activos únicos que solo se encuentran en este tipo de propóleo, con destaque para el Artepelin C, compuesto al que muchos investigadores atribuyen gran parte de su actividad.
Diversos estudios indican que, además de los componentes tradicionales del propóleo, el Artepelin C es responsable por atribuir al propóleo verde las siguientes actividades: antimicrobiana, antiinflamatoria, antitumoral, antioxidante e inmunomoduladora.
Estandarización exclusiva EPP-AF®
Producido mediante un proceso exclusivo de estandarización de Apis Flora, el Extracto de Própolis Apis Flora presente en la composición del PROPOMAX® Clinical Propolis Spray está caracterizado química y biológicamente, y pasa por más de 100 análisis de control de calidad, garantizando excelencia en cuanto a producto natural.